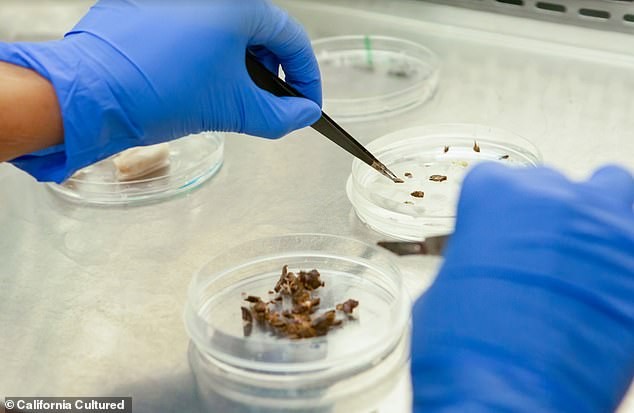
Како се создава лабораториската чоколада? Брза наука наместо години чекање на насади

Шокантна револуција: Дали ќе јадеме лабораториска чоколада додека вистинската станува луксуз?
Со постојаниот пораст на цените на какаото и огромното влијание што неговото производство го има врз животната средина, станува сè појасно дека ни се потребни нови начини да уживаме во чоколадото. Американската компанија California Cultured, преку одгледување на какао-клетки во лабораторија, создава одржлива чоколада која можеби ќе го промени начинот на кој го доживуваме овој омилен десерт. Дали светот е подготвен за новата чоколадна реалност, што ветува ист вкус, но со далеку помало еколошко влијание?

In This Article:
- Лабораториски одгледана чоколада од клетки на какао – револуција што може да го спаси шумите
- Како се создава лабораториската чоколада? Брза наука наместо години чекање на насади
- Вкусот на иднината: Чоколадо со препознатлив, но уникатен вкус – подалеку од евтините замени
- Чоколадо во продавниците од 2028 – од скапа новина до достапност за сите
- Одржливост без граници: Чоколадо од лабораторија насекаде низ светот – а не во уништените тропски шуми
- Чоколадната индустрија е еколошка катастрофа – лабораториската чоколада може да го промени тоа
Лабораториски одгледана чоколада од клетки на какао – револуција што може да го спаси шумите
California Cultured развива чоколада која се создава не од зрна, туку од клетки на какао, одгледани во лабораторија. Главниот извршен директор, Алан Перлстајн, изјави: „Култивацијата на чоколадото доведе до уништување на голем дел од неостварените тропски шуми во светот. Сега, со недостаток на какао и проблеми со квалитетот, гледаме како лоши имитации ги заменуваат класиците од нашето детство. Ние можеме да го смениме сето тоа со технологијата што ја развиваме.“ Тимот испрати мал примерок, со големина на зрно кафе, и веднаш се гледа дека ова е далеку подобро од евтините чоколади преполни со палмино масло.

Како се создава лабораториската чоколада? Брза наука наместо години чекање на насади
Процесот започнува со земање на клетки од зрна какао, кои потоа се култивираат на плочи во лабораторија, хранети со мешавина од хранливи материи и шеќери. Овие клетки се размножуваат неколку дена наместо месеците или годините потребни кај традиционалното одгледување на какао. „Успеваме да ги измамиме растителните клетки да мислат дека сè уште се во почвата и ги натераме да растат бескрајно. Кога ќе достигнеме одредено ниво на раст, ги собираме и трансформираме во чоколада“, објаснува Перлстајн. Примерокот што го пробав содржи лабораториски одгледан какао прав, шеќер и какао путер и веднаш се топи на прстот – како вистинското чоколадо.

Вкусот на иднината: Чоколадо со препознатлив, но уникатен вкус – подалеку од евтините замени
Кога се топи на јазикот, лабораториската чоколада има познат, благо горчлив вкус со суптилен растителен шмек. Не е најдобрата чоколада што сум ја пробал – за тоа сè уште води York Cocoa Works од Велика Британија, која е богата и комплексна. Но, оваа лабораториска верзија е далеку над евтините чоколади кои ги среќаваме во новогодишните календари и на нашите бисквити. Ако не знаев што е, можеби ќе забележев дека нешто е различно, но не би можел да кажам што точно.

Чоколадо во продавниците од 2028 – од скапа новина до достапност за сите
Според Алан Перлстајн, потрошувачите ќе можат да го купат производот на California Cultured околу 2028 година. Во почетокот, лабораториски одгледаното чоколадо ќе чини меѓу 15 и 20 долари (околу 14 до 19 евра), но со зголемување на производството цената би паднала. „Наша намера е да ја спуштиме цената до нивото на конвенционалните чоколадни производи во рок од четири години од излегувањето на пазарот“, изјавува Перлстајн.

Одржливост без граници: Чоколадо од лабораторија насекаде низ светот – а не во уништените тропски шуми
Какаото традиционално се одгледува само во тропските региони што се наоѓаат на околу 20 степени северно и јужно од екваторот. Земји како Гана, Брегот на Слоновата Коска, Камерун, Нигерија, Индонезија и Еквадор го водат производството. Лабораториската иновација, пак, овозможува чоколадото да се произведува било каде – дури и блиску до потрошувачите. Перлстајн вели: „Наместо во оддалечени дождовни шуми, сакаме да го одгледуваме чоколадото таму каде што луѓето живеат за да можат да го видат и разберат пред да го вкусат.“
Чоколадната индустрија е еколошка катастрофа – лабораториската чоколада може да го промени тоа
Широката критика кон чоколадото како индустриски продукт се должи на тоа што одгледувањето на какаото предизвикува сеча на шуми, губење на биодиверзитет и огромна потрошувачка на вода. Дополнително, употребата на адитиви како млеко, шеќер и палмино масло уште повеќе го зголемуваат негативното влијание. Истражување од Универзитетот во Манчестер покажало дека индустријата за чоколадо во Велика Британија произведува околу 2,1 милион тони стакленички гасови годишно – еквивалентно на емисиите на еден град со големина на Белфаст. За само една чоколадна табла потребни се околу 1.000 литри вода. Употребата на пестициди, исто така, доведува до контаминација.


